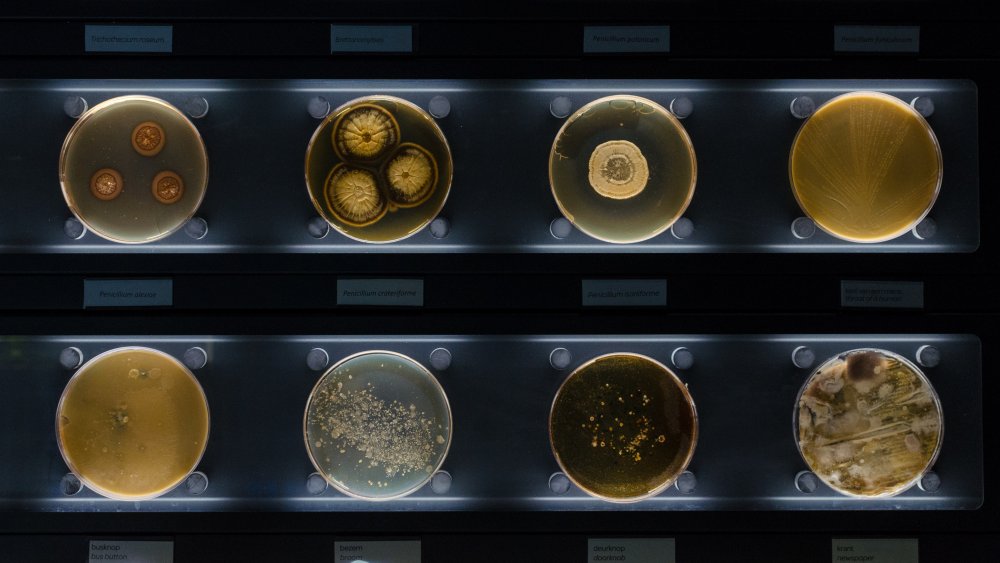
Bactéries au microscope

Savoir : téléphone sale et microbiologie quotidienne

Le téléphone ressemble aujourd’hui à une extension de notre corps : on s’en sert pour communiquer, s’occuper au travail ou regarder des vidéos dans des moments d’inaction. Cette proximité constante fait du téléphone un réservoir idéal pour toutes sortes de microbes. En observant ce contraste, des chercheurs ont même rapproché le rôle moderne du portable d’un organe autrefois jugé inutile, l’appendice, qui pourrait pourtant protéger certaines bactéries intestinales (Time).
De façon tout aussi surprenante, des études publiées au cours des dernières années montrent que nos téléphones sont couverts de bactéries en quantité souvent supérieure à celle relevée sur des sièges de toilettes. En 2017, des chercheurs ont ainsi estimé qu’un téléphone contenait jusqu’à dix fois plus de bactéries qu’un siège de toilette ; une estimation qui a été révisée à environ sept fois plus sale dans une publication de 2019, ce qui donne toutefois une idée claire du problème.
Les microbes qu’on retrouve sur un téléphone
La plupart des germes détectés sur les téléphones ne provoquent pas forcément de maladie, mais certains agents pathogènes préoccupants y ont été identifiés :
- Streptocoques — bactérie pouvant causer angine, syndrome du choc toxique ou infections cutanées graves (MedlinePlus).
- Escherichia coli (E. coli) — liée à des troubles digestifs sévères, vomissements et diarrhées (MedlinePlus).
- MRSA — staphylocoque résistant aux antibiotiques, responsable d’abcès douloureux et d’infections profondes (Mayo Clinic).
La détection de ces germes ne signifie pas automatiquement une infection. Pourtant, leur présence souligne un risque de contamination indirecte : on porte fréquemment le téléphone au visage, on le pose sur des surfaces variées, et il peut recoloniser les mains même après les avoir lavées.
Pour limiter la prolifération, il est donc prudent d’intégrer le nettoyage régulier du téléphone à sa routine d’hygiène. Après tout, il est fort possible que la cuvette des toilettes soit, paradoxalement, plus propre que l’écran que l’on touche des dizaines de fois par jour.
En liaison avec les sections suivantes, on examinera comment désinfecter efficacement son appareil et quelles pratiques simples adopter pour réduire la charge microbienne sans endommager son téléphone.

